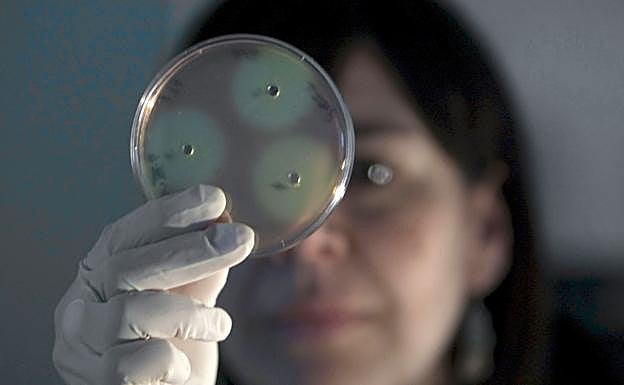
Una investigadora trabajando en el A&B Laboratorios de Biotecnología, en Vitoria.

España, lejos de los países más innovadores
INNOVACIÓN ·
Baja actividad de patentes, bajo valor añadido en la fabricación y escasa densidad tecnológica. Así ve Bloomberg a EspañaJOSÉ A. GONZÁLEZ
Madrid
Jueves, 7 de febrero 2019, 07:11
Gastos de investigación y desarrollo, capacidad de fabricación, concentración de empresas públicas de alta tecnología. Estos son algunos de los criterios que cada año Bloomberg examina con lupa para realizar su índice anual de innovación y un año más España saca un aprobado casi raspado.
Lejos de los países más innovadores, según este índice, España se sitúa en la posición número 30 por detrás de Rumanía, Malasia y Rusia con una puntuación de 64,52 sobre 100 puntos. Un año más, el país más innovador es Corea del Sur con 87,38 puntos, seguido muy de cerca por Alemania, impulsado por la fuerza del valor agregado de la fabricación y la intensidad de la investigación.
En las categorías establecidas por Bloomberg, España está en el vagón de cola en la lista de los 60 elegidos. Solo destaca en la eficiencia terciaria, mientras que los peores datos los registra en patentes (44 de 60).
En 2017, el registro de patentes cayó un 20%, en 2016, un 2% y en los años anteriores la resta fue del 5%. Una caída que se ha acentuado este pasado 2018, cuando, según la Oficina Española de Patentes y Marcas (OEPM), se solicitaron un total de 1.576 Patentes Nacionales, 710 menos que en 2017 y 1.273 menos que en 2016, lo que supone un descenso del 31,06%.
Precisamente, el punto fuerte de China se centra en el apartado de patentes. Este punto de apoyo ha permitido subir cinco posiciones al gigante asiático y superar a Reino Unido. Impulso generado especialmente por los equipos de investigación de Huawei y BOE Technology Group.
Un salto que le vale para alcanzar la posición 16 en la clasificación, ya que Pekín queda penalizado por la escasa productividad y la concentración de investigadores. La actividad de patentes también aumentó los puntajes para Israel, que fue un gran ganador al saltar cinco puestos al quinto lugar en general. El país del Medio Oriente superó a Singapur, Suecia y Japón en el proceso.
Por su parte, los Estados Unidos de Donald Trump se recuperan del varapalo innovador de 2018 al recuperar las privilegiadas plazas del Top 10. EE UU salta a la octava posición gracias a los ciclos de productos más rápidos y la intensificación de la competencia están cambiando las formas en que los gerentes tienen que trabajar,
Su liderazgo en patentes y una potente densidad de alta tecnología le permiten recuperar tres posiciones en esta edición del índice de países innovadores de Bloomblerg. Basado en datos de fuentes como el Banco Mundial, el FMI y la OCDE, la lista anual tiene en cuenta parámetros como el gasto en investigación y desarrollo como porcentaje del PIB, capacidades de fabricación, productividad, actividad de patentes, concentración de investigadores y concentración de empresas de alta tecnología.
«La batalla por el control de la economía global en el siglo XXI se ganará y se perderá por el control de tecnologías innovadoras. El puesto número uno de Corea y el cambio de China en la clasificación es un recordatorio de que la guerra comercial de EE UU podría desacelerarse pero no detendrá el auge tecnológico de Asia», explican los expertos de Bloomberg.